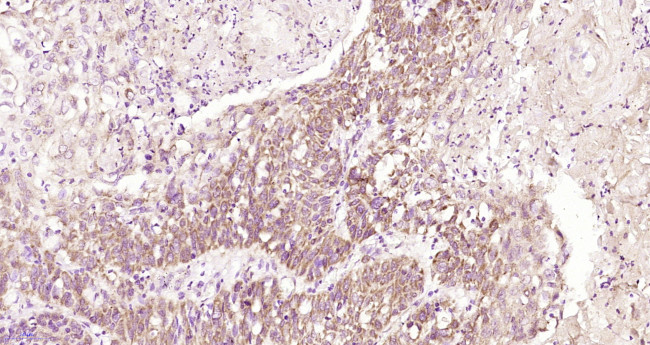
TEM8 Antibody in Immunohistochemistry (Paraffin) (IHC (P))

Search
Bioss
TEM8 Polyclonal Antibody
{{$productOrderCtrl.translations['antibody.pdp.commerceCard.promotion.promotions']}}
{{$productOrderCtrl.translations['antibody.pdp.commerceCard.promotion.viewpromo']}}
{{$productOrderCtrl.translations['antibody.pdp.commerceCard.promotion.promocode']}}: {{promo.promoCode}} {{promo.promoTitle}} {{promo.promoDescription}}. {{$productOrderCtrl.translations['antibody.pdp.commerceCard.promotion.learnmore']}}
图: 1 / 1
TEM8 Antibody (BS-15583R) in IHC (P)

产品信息
BS-15583R
种属反应
宿主/亚型
分类
类型
抗原
偶联物
形式
浓度
规格
纯化类型
保存液
内含物
保存条件
运输条件
靶标信息
This gene encodes a type I transmembrane protein and is a tumor-specific endothelial marker that has been implicated in colorectal cancer. The encoded protein has been shown to also be a docking protein or receptor for Bacillus anthracis toxin, the causative agent of the disease, anthrax. The binding of the protective antigen (PA) component, of the tripartite anthrax toxin, to this receptor protein mediates delivery of toxin components to the cytosol of cells. Once inside the cell, the other two components of anthrax toxin, edema factor (EF) and lethal factor (LF) disrupt normal cellular processes. Three alternatively spliced variants that encode different protein isoforms have been described.
仅用于科研。不用于诊断过程。未经明确授权不得转售。
篇参考文献 (0)
生物信息学
蛋白别名: 2310008J16Rik; 2810405N18Rik; anthrax toxin receptor; Anthrax toxin receptor 1; ATR; FLJ10601; FLJ11298; FLJ21776; Tem-8; Tumor endothelial marker 8; unnamed protein product
基因别名: 2310008J16Rik; 2810405N18Rik; Antrx1; ANTXR1; ATR; GAPO; TEM8
UniProt ID: (Human) Q9H6X2, (Rat) Q0PMD2, (Mouse) Q9CZ52
Entrez Gene ID: (Human) 84168, (Rat) 362393, (Mouse) 69538